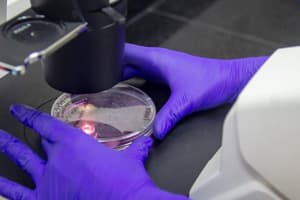

Newsletter DPT Nro. 95/97 - Abril/Junio
ISSN 2618-236X
Abril-Junio / 2024
NOTICIAS DESTACADAS
Asamblea de las Naciones Unidas sobre el Medio Ambiente - 6ª sesión (UNEA-6); Nairobi, Kenia. 1/03/2024.
Resoluciones para aplacar la triple crisis planetaria
La Asamblea de las Naciones Unidas para el Medio Ambiente (UNEA) es el máximo órgano mundial en su materia. Aunque sus resoluciones no son jurídicamente vinculantes, se consideran un relevante primer paso hacia los acuerdos medioambientales mundiales y la elaboración de políticas nacionales. El 1° de marzo concluyó, en Nairobi (Kenia), la 6ª edición de la Asamblea (UNEA-6), la cual registró un récord de 7.000 delegados de 182 países miembros, entre ellos 170 ministros, así como expertos, activistas y representantes de la industria. Se aprobaron 15 resoluciones y 2 decisiones que abarcan temas como gestión de productos químicos y residuos, contención de la desertificación y la degradación del suelo, y fortalecimiento de las políticas hídricas. Además, en una declaración ministerial, los países se comprometieron a colaborar en la negociación de un instrumento internacional jurídicamente vinculante sobre la contaminación por plásticos.

Hacia la “Cumbre para la Transformación de la Educación” convocada por la ONU
Piden que el año 2024 sea un punto de inflexión en materia educativa
Pautas Regulatorias para Sistemas con Inteligencia Artificial
Relevantes experiencias pioneras

NOTICIAS DE INTERES GENERAL

Empresas de biotecnología en la Argentina: Indicadores clave de un sector en crecimiento
Una exposición en el IUD
Contribución de las Instituciones de Educación Superior
A la sostenibilidad de sus entornos locales


Lucha contra enfermedades trasmitidas por mosquitos
¿Combatir contra los mosquitos o contra los patógenos que trasmiten?
NOTICIAS CIENTIFICAS
NOTICIAS CIENTIFICAS NACIONALES
Especialistas del CONICET y la UBA procuran mejorar el rendimiento y la calidad de cultivos de granos
Mediante actividades, productos y servicios, en programas de vinculación tecnológica

Patentan una nueva molécula para combatir el Parkinson
Diseñada por un equipo del CONICET, la UBA y la UNT, con la colaboración de la empresa biotecnológica Sky Bio LLC
NOTICIAS CIENTIFICAS INTERNACIONALES
Proteínas: Avances en la predicción, creación y mapeo de interacciones con otras biomoléculas


Avances en el conocimiento del cerebro humano
Con alto potencial clínico y computacional
NOTICIAS EDUCATIVAS Y PEDAGOGICAS
NACIONALES Y REGIONALES
CONICET: Repositorio de Datos de Investigación
Para contribuir al avance del conocimiento y facilitar la reutilización para nuevas y futuras investigaciones


Programa +DES (+ Desarrollo: Innovación, Inspiración y Transformación en Educación Superior)
Está abierta la inscripción para webinarios sobre temáticas de notoria actualidad
RESEÑAS DE ARTÍCULOS INTERNACIONALES
El fraude en la investigación-publicación científico-tecnológica – Primera parte
Fraude tradicional: Tipología, magnitud, motivaciones y estrategias de prevención, detección y control


EE.UU.: Cuestionan exigencias de las universidades a sus profesores titulares en carreras de medicina
A la espera de fallos judiciales
Nota del Editor: El editor no se responsabiliza por los conceptos u opiniones vertidos en las entrevistas, artículos y documentos reseñados en este Newsletter, los cuales son de exclusiva responsabilidad de los respectivos entrevistados, autores o colaboradores.

STAFF DEL NEWSLETTER DPT
Sr. Guillermo Gómez Galizia
Presidente de la Fundación para el Desarrollo Productivo y Tecnológico Empresarial de la Argentina (DPT)
Lic. José Luis Tesoro
Coordinador Editorial
Prof. Martin Emmanuel Bracamonte
Colaborador
ISSN 2618-236X


